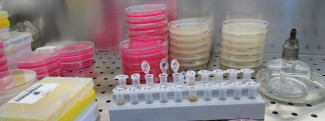

Johns Hopkins UniversityEst. 1876
America’s First Research University
Communicating U.S. Science Policy

The complexity of scientific research does not always mesh well with transparency. Terror incidents in the 1990s led to rules "that undermined the ability of scientists and research institutions to self-regulate and in some cases to disseminate information freely," according to Carole R. Baskin, Director, Communicable Diseases, Vector & Animal Control for St Louis County, Mo. She recently published an essay titled "Who Should Be Driving US Science Policy?" in Perspectives in Biology in Medicine. Baskin joined us for a Q&A about her article, which strives to find ways to balance competing needs for transparency and security, so that research critical to biosecurity is supported rather than impeded.
What pushed you to write this essay?
How important is it for scientists to take a more active role in policy discussions?
Even in the best of circumstances, members of Congress have limited time and ability to understand science and especially emerging technologies. They must rely on scientists to help them interpret the slew of information, some very misleading, they and their constituents receive every day. Unfortunately, scientists, with the exception of individuals at the pinnacle of their career, are very hesitant to chime in with their senators and representatives. The reasons have to do with how scientists are trained: they might fear not being completely accurate unless the topic is within their very specialized area of expertise, they are afraid they will be misquoted or misinterpreted. One thing you have to understand is that scientific writing does not lend itself well to sound bites and unequivocal statements. This is a fear that, in my view, scientists have to get over if they are to serve the public.

How difficult is it to walk a fine line between informing the public and risking controversy when the general public misinterprets or misuses information?
The public gets information, regardless of whether scientists have a hand in it or not. The flow of news never stops and it may be inaccurate because of a taste for sensationalism or because the news comes from tertiary sources, i.e. from outlets doing no investigative work themselves but gathering information from other sources for profits in the form of 'click baits'. Once misinformation is out, it is easily spread through social media. Scientists should recognize that they can only control what *they* do, but that the presence of misinformation does not absolve them from their duty to inform others with accurate facts. If their messages become distorted, it is also their duty to issue corrections and clarifications. Scientists often depend on public dollars to do their research, so one form of repayment is to provide the public service to educate lay people.
What lessons have been learned in the past 40 years or so about how scientists can best communicate with the public about heir research?
I believe that what we have learned is that scientists should follow the same principles as any official source dealing with the public. These principles are the ones we call 'crisis communication' but that can be applied to any communication of information important for public welfare: 'Be first', i.e. be proactive in communicating with the public, don't wait for a story to come out in the news; 'be right', or be accurate, but tailor your message for a lay audience; 'be honest', this goes without saying, trust is paramount; 'promote action', so give people resources they can go to or something they can do to empower them with this new information; and finally, 'show respect', which means that just because lay people do not have the same training does not mean that they cannot grasp the information or that they are not worthy to be informed.


